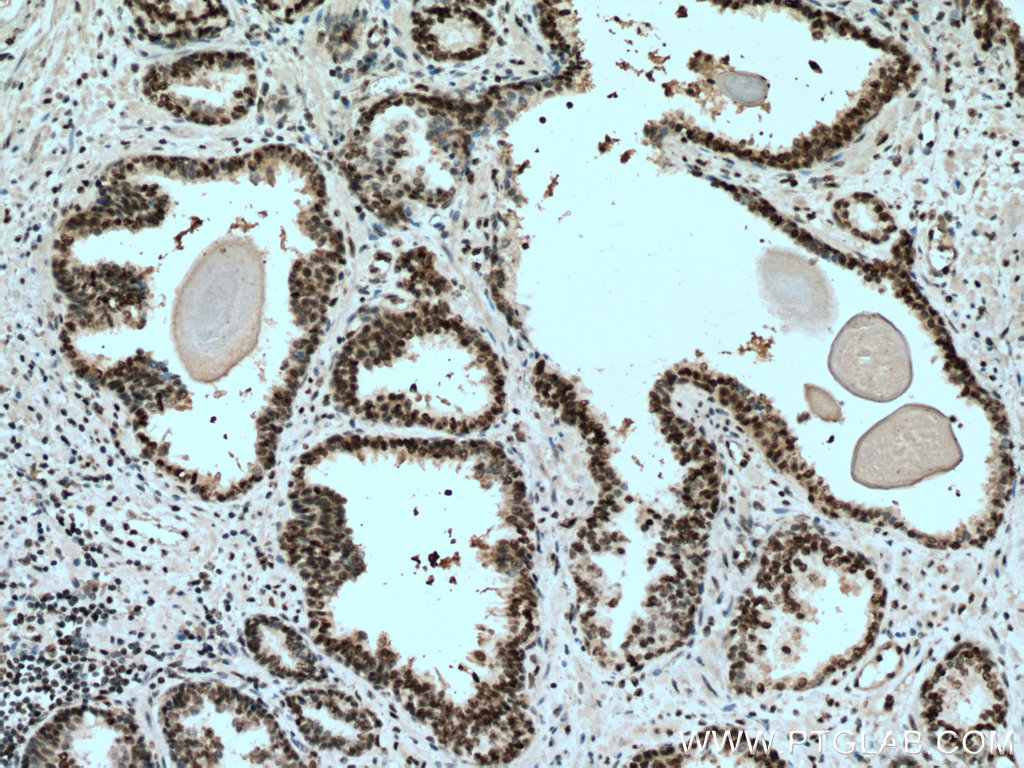

验证数据展示
产品信息
67154-1-PBS targets SUMO2/3 in WB, IHC, IF/ICC, Indirect ELISA applications and shows reactivity with human, mouse, rat samples.
| 经测试应用 | WB, IHC, IF/ICC, Indirect ELISA Application Description |
| 经测试反应性 | human, mouse, rat |
| 免疫原 |
CatNo: Ag28672 Product name: Recombinant human SUMO2/3 protein Source: e coli.-derived, PET28a Tag: 6*His Domain: 1-95 aa of BC008450 Sequence: MADEKPKEGVKTENNNHINLKVAGQDGSVVQFKIKRHTPLSKLMKAYCERQGLSMRQIRFRFDGQPINETDTPAQLEMEDEDTIDVFQQQTGGVY 种属同源性预测 |
| 宿主/亚型 | Mouse / IgG2b |
| 抗体类别 | Monoclonal |
| 产品类型 | Antibody |
| 全称 | SMT3 suppressor of mif two 3 homolog 2 (S. cerevisiae) |
| 别名 | SUMO2, Small ubiquitin-related modifier 2, Sentrin-2, Sentrin2, Sentrin 2 |
| 计算分子量 | 11 kDa |
| 观测分子量 | 18 kDa |
| GenBank蛋白编号 | BC008450 |
| 基因名称 | SUMO2 |
| Gene ID (NCBI) | 6613 |
| RRID | AB_2882451 |
| 偶联类型 | Unconjugated |
| 形式 | Liquid |
| 纯化方式 | Protein A purification |
| UNIPROT ID | P61956 |
| 储存缓冲液 | PBS only, pH 7.3. |
| 储存条件 | Store at -80°C. The product is shipped with ice packs. Upon receipt, store it immediately at -80°C |
背景介绍
Ubiquitin is most famous for its function in targeting proteins for degradation by the 26S proteasome, ubiquitin needs to be attached to a substrate in chains (polyubiquitylation) before being recognized by proteasome. Similarly, SUMO (small ubiquitin-related modifier) can be linked to substrates in chains (polysumoylation), SUMO modification has been implicated in many important cellular processes including the control of genome stability, signal transduction, targeting to and formation of nuclear compartments, cell cycle and meiosis. There are 4 confirmed SUMO isoforms in human, SUMO-1, SUMO-2, SUMO-3 and SUMO-4. SUMO-2 and SUMO-3 are nearly identical but are distinct from SUMO-1. SUMO2/3 conjugation was recently widely involved in neuroprotective activities. A substitution (M55V) of SUMO4 was strongly associated with the pathogenesis of type 1 diabetes (T1D) involving NF kappa B related mechanisms.